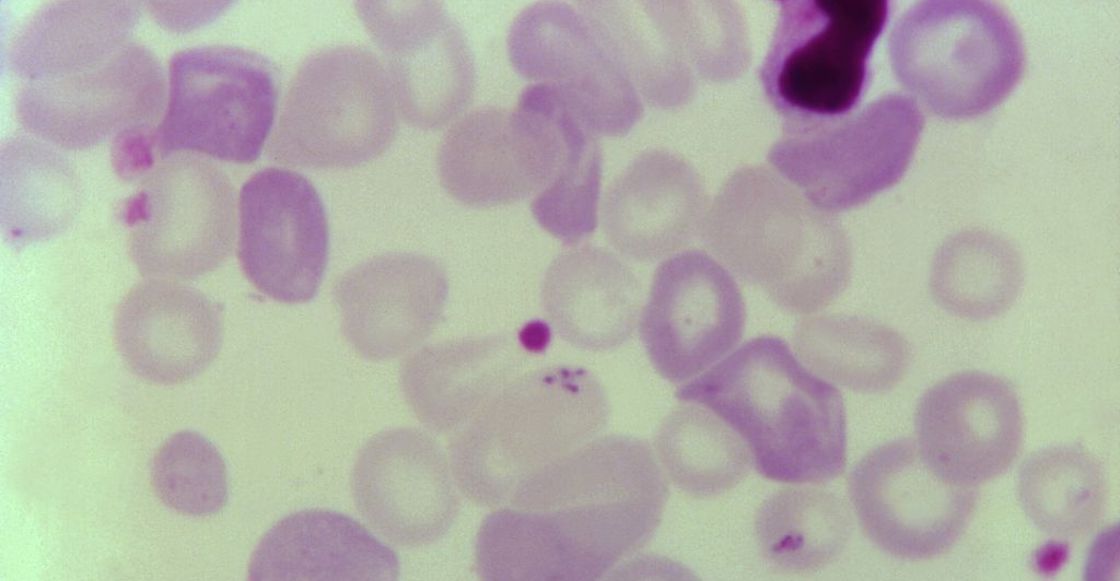

Este pasado miércoles 30 de junio, la Organización Mundial de la Salud (OMS) anunció que China está oficialmente libre de malaria. De esta manera, se convierte en el primer país del Pacífico Occidente en deshacerse de esta enfermedad mortal.
¿Qué informó la OMS sobre la malaria en China?
La OMS declaró que China oficialmente está libre de malaria, con lo que se convierte en el primer país de la región del Pacífico Occidental en eliminar esta enfermedad mortal parasitaria transmitida por la picadura de un mosquito, que mata a alrededor de 400 mil personas al año en todo el mundo, la mayoría de ellas, niños menores de cinco años.
Al respecto, el director general de la Organización, Tedros Adhanom Ghebreyesus, indicó lo siguiente por medio de un comunicado: “Hoy felicitamos al pueblo de China por librar al país de la malaria”.

“Su éxito se lo han ganado a pulso y ha sido posible tras décadas de acción específica y sostenida. Con este anuncio, China se une al creciente número de países que están demostrando al mundo que un futuro sin malaria es un objetivo viable”, agregó.
Y es que los casos de malaria en China han disminuido mucho desde el 2000. Por ello, en 2020, después de informar de cuatro años consecutivos de cero casos, el país asiático pidió una certificación oficial de la OMS de eliminación de la malaria, la cual le fue dada esta semana.

China se suma a otros países libres de malaria
China se suma a otros países de todo el mundo libres de malaria, en específico a 40 naciones y territorios como Australia, Singapur y Brunei. Esto representa un gran logro para el país asiático, ya que había sido un gran problema en la década de 1940, con cerca de 30 millones de casos por año.
Aunque China ya fue declarada libre de malaria, la OMS advirtió que ésta aún podría regresar. Sin embargo, aceptaron que tienen un buen programa de vigilancia y control de esta enfermedad para evitar su restablecimiento.
Finalmente, cabe señalar que no existe ninguna vacuna autorizada contra la malaria, aunque se están desarrollando algunas, Por ejemplo, una de ellas ha mostrado grandes niveles de eficacia en ensayos clínicos realizados este año.
*Con información de CNN

